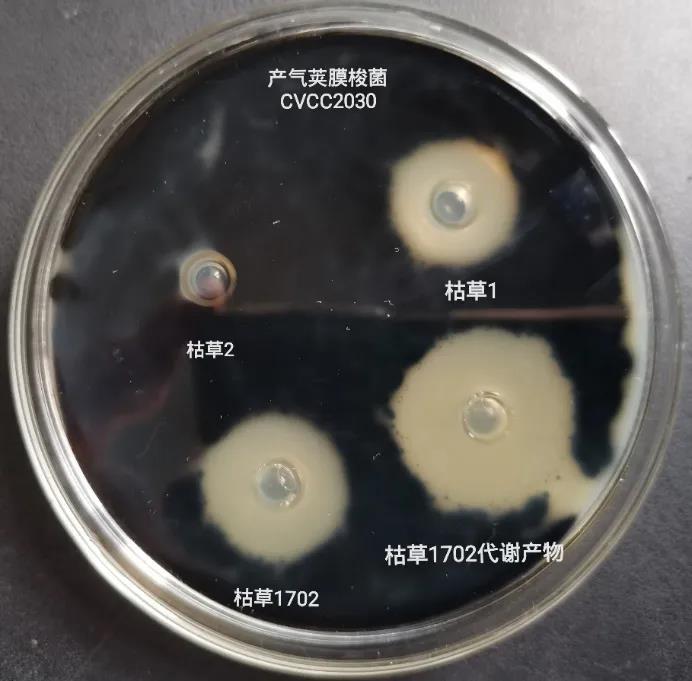
1.jpg

2021年家禽饲料和营养调查了全球各地560位家禽生产者、营养学家和饲料制造商。从调查的结果我们可以看出家禽养殖面临的一些问题,主要表现一下几个方面:
2021年WATT发布了最新一期调查数据显示,抗生素减量及禁用带来的挑战最大。38%的受访者称抗生素限令对2021年生产的影响最大。

根据调查,32%的受访者认为无抗家禽的饲料配方成本比传统配方高出1%到5%;18%的受访者表示,他们的无抗饲料成本增加了5%到10%,那么寻找有效的性价比高的抗生素替代品将是最佳的选择。81%的受访者表示,益生菌和有机酸是最有效的抗生素替代品,而益生菌是性价比最高的抗生素替代品。
由于禁止或减少家禽饲料中的抗生素使用,受访者指出,坏死性肠炎(55%)、球虫病(49%)和坏疽性皮炎(39%)发病率增加(如下图)。坏死性肠炎对肉鸡是由产气荚膜梭菌引起的,对肉鸡生产性能影响特别大。由坏死性肠炎导致的肉鸡死亡率约为2~10%,在极端情况下会高达50%,而对肉鸡生产性能的影响非常巨大,鸡群精神萎靡、采食量下降、消化率降低、料比增加、出现饲料便、水便等现象;蛋鸡死亡率也高达6.5%。全球每年因坏死性肠炎导致的肉鸡养殖业经济损失高达20亿美元以上。

除此之外,球虫病也对梭菌性坏死性肠炎有促进作用。球虫会引起肠粘膜出血,出血的肠粘膜给肠道内梭菌提供生长所需的营养(梭菌具有嗜血性),导致肠道内梭菌急剧繁殖,急剧繁殖的梭菌产生大量的外毒素,而外毒素进一步破坏肠粘膜,最终引发坏死性肠炎,导致动物生产性能下降,严重情况下导致动物死亡。

PA视讯公司生产的枯草芽孢杆菌1702是经过特定选育的菌种,针对产气荚膜梭菌所引起的坏死性肠炎有特别的抑制作用(见下图)。

枯草芽孢杆菌1702有效杀灭产气荚膜梭菌,在肉鸡养殖过程中添加枯草芽孢杆菌可显著改善肉鸡肠道功能,促进肉鸡肠道消化吸收,同时抑制病源菌的生长,防治疾病发生。在肉鸡产气荚膜梭菌攻毒试验中,添加速必康1702可显著抑制肉鸡肠道中产气荚膜梭菌的量,与12ppm的恩拉霉素(CP+ENRA)相比,添加300ppm(CP+BSI)的速必康1702就能达到同样的效果,产气荚膜梭菌数量急剧下降。

注:CON,对照组;CP梭菌攻毒组;CP+ENRA,梭菌攻毒+12ppm恩那霉素治疗组;CP+BSI,梭菌攻毒+300ppm速必康1702;CP+BSII,梭菌攻毒+500ppm速必康1702。